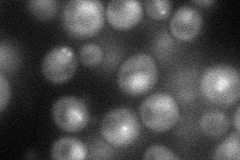
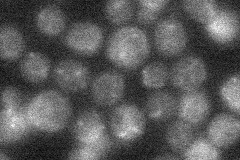
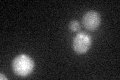
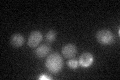

View description
Kinetochore protein of unknown function; associated with the essential kinetochore proteins Nnf1p and Spc24p; phosphorylated by both Clb5-Cdk1 and, to a lesser extent, Clb2-Cdk1.
Localization:
Intensity:
Fold change:
Significance:
-
C’ GFP library in SD

punctate18.74 -
N' NOP1pr-GFP in SD
cytosol,punctate,nucleus39.7109 -
N' TEF2pr-mCherry in SD

punctate,nucleus9.16429 -
N' NATIVEpr-GFP in SD
punctate19.7331 -
N' TEF2pr-VC and Cyto-VN in SD

below threshold22.7697 -
C’ GFP library in SD+DTT
punctateN/AN/ANo -
C’ GFP library in SD+H2O2

punctate16.140.86No -
C’ GFP library in Starvation Media
punctate25.731.37No -
C’ GFP library on the background of Pup2-DaMP

punctate -
C’ GFP library on the background of CCT mutant

punctate18.4290.982742No
